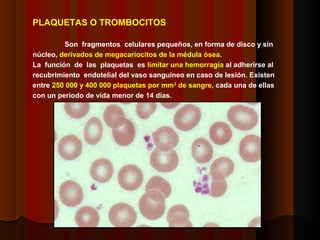
PLAQUETAS O TROMBOCITOS
Son fragmentos celulares pequeños, en forma de disco y sin
núcleo, derivados de megacariocitos de la médula ósea.
La función de las plaquetas es limitar una hemorragia al adherirse al
recubrimiento endotelial del vaso sanguíneo en caso de lesión. Existen
entre 250 000 y 400 000 plaquetas por mm3
de sangre, cada una de ellas
con un periodo de vida menor de 14 días.
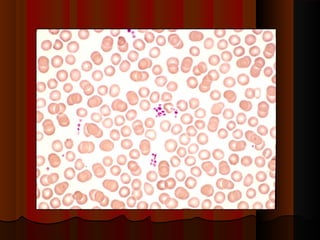
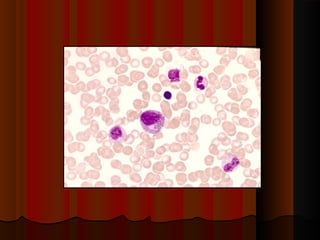
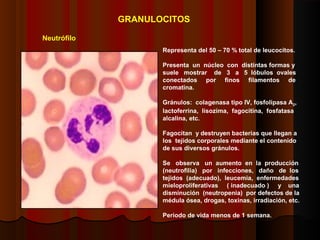
Neutrófilo
Representa del 50 – 70 % total de leucocitos.
Presenta un núcleo con distintas formas y
suele mostrar de 3 a 5 lóbulos ovales
conectados por finos filamentos de
cromatina.
Gránulos: colagenasa tipo IV, fosfolipasa A2,
lactoferrina, lisozima, fagocitina, fosfatasa
alcalina, etc.
Fagocitan y destruyen bacterias que llegan a
los tejidos corporales mediante el contenido
de sus diversos gránulos.
Se observa un aumento en la producción
(neutrofilia) por infecciones, daño de los
tejidos (adecuado), leucemia, enfermedades
mieloproliferativas ( inadecuado ) y una
disminución (neutropenia) por defectos de la
médula ósea, drogas, toxinas, irradiación, etc.
Periodo de vida menos de 1 semana.
GRANULOCITOS
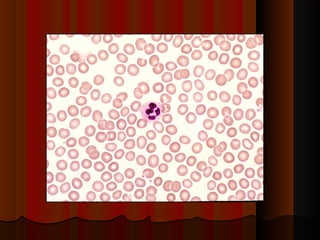
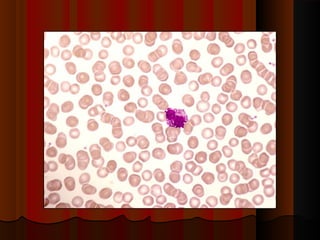
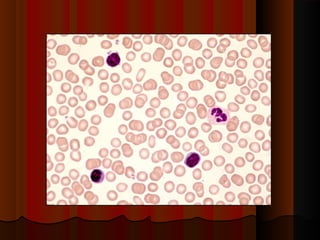
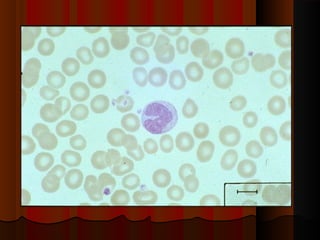
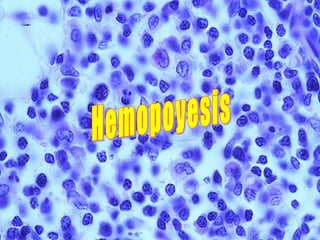

Este documento describe los componentes de la sangre y sus funciones. La sangre está compuesta de plasma, plaquetas, glóbulos rojos, y glóbulos blancos. El plasma transporta nutrientes, desechos, hormonas e inmunoglobulinas. Las plaquetas ayudan a formar coágulos para detener hemorragias. Los glóbulos rojos transportan oxígeno y dióxido de carbonio usando la hemoglobina. Los glóbulos blancos combaten infecciones y producen anticuerpos. La médula ósea produce todas